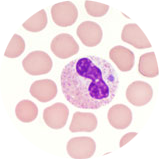
Anaplasmosis blood smear

Anaplasmosis
- Home
- Tick ID
- Overview of Tickborne Diseases
- Lyme Disease
- Tickborne Relapsing Fever (TBRF)
- Hard Tick Relapsing Fever
- Anaplasmosis
- Ehrlichiosis
- Rocky Mountain Spotted Fever
- Rickettsia parkeri Rickettsiosis
- Tularemia
- Babesiosis
- Heartland and Bourbon Virus Diseases
- Colorado Tick Fever
- Powassan Virus Disease
- Tickborne Diseases Abroad
- Tick Bites/Prevention
- Lyme Disease Prophylaxis After Tick Bite
Agent
Anaplasma phagocytophilum
Anaplasmosis was formerly known as Human Granulocytic Ehrlichiosis (HGE).
Severe and life-threatening illness is less common with anaplasmosis compared to other rickettsial diseases, such as Rocky Mountain spotted fever (RMSF) or E. chaffeensis ehrlichiosis. While the case-fatality rate among patients who seek care for the illness is <1%, predictors of a more severe course include advanced age, immunosuppression, comorbid medical conditions, and delay in diagnosis and treatment.
Where Found
Anaplasmosis is most frequently reported from the Upper Midwest and northeastern United States in areas that correspond with the known geographic distribution of Lyme disease and other Ixodes scapularis-transmitted diseases. Due to the common vector, co-infection with A. phagocytophilum and B. burgdorferi, Babesia microti, or Powassan virus is possible; illness may be marked by a more severe course or incomplete response to treatment.
A. phagocytophilum is typically transmitted by the bite of an infected tick but may also be associated with blood product transfusions or organ transplant.
Incubation Period
5–14 days
Signs and Symptoms
- Fever, chills, rigors
- Severe headache
- Malaise
- Myalgia
- Gastrointestinal symptoms (nausea, vomiting, diarrhea, anorexia)
- Rash (<10%)
The Signs and Symptoms list presents symptoms commonly seen with anaplasmosis. However, it is important to note that few people will develop all symptoms and the number and combination of symptoms varies greatly from person to person.

CONFIRMATION OF THE DIAGNOSIS IS BASED ON LABORATORY TESTING, BUT ANTIBIOTIC THERAPY SHOULD NOT BE DELAYED IN A PATIENT WITH A SUGGESTIVE CLINICAL PRESENTATION.
General Laboratory Findings
Typically observed during the first week of clinical disease:
- Mild anemia
- Thrombocytopenia
- Leukopenia (characterized by relative and absolute lymphopenia and a left shift)
- Mild to moderate elevations in hepatic transaminases
Visualization of morulae in the cytoplasm of granulocytes during examination of blood smears is highly suggestive of a diagnosis; however, blood smear examination is insensitive and should never be relied upon solely to rule anaplasmosis in or out.
LABORATORY DIAGNOSIS
- Detection of DNA by PCR of whole blood. This method is most sensitive during the first week of illness; sensitivity may decrease after administration of tetracycline-class antibiotics.
- Demonstration of a four-fold rise in IgG-specific antibody titer by indirect immunofluorescence antibody (IFA) assay in paired serum samples. The first sample should be taken within the first 2 weeks of illness and the second should be taken 2 to 4 weeks later.
- Immunohistochemical (IHC) staining of organism from skin, tissue, or bone marrow biopsies.
NOTE: Antibody titers are frequently negative in the first 7–10 days of illness. Acute antibody results cannot independently be relied upon for confirmation.
NOTE: IgM antibodies are less specific than IgG antibodies and are more likely to generate false positives. IgM results alone should not be used for laboratory diagnosis.
Treatment
Anaplasmosis, ehrlichiosis, and spotted fever group rickettsioses are treated with doxycycline. Clinical suspicion of any of these diseases is sufficient to begin treatment. Delay in treatment may result in severe illness and even death. These regimens may need to be adjusted depending on a person’s age, medical history, underlying health conditions, pregnancy status, or allergies. Consult an infectious disease specialist in cases of pregnancy or life-threatening allergy to doxycycline.
| Age Category | Drug | Dosage | Maximum | Duration (Days) |
|---|---|---|---|---|
| Adults | Doxycycline | 100 mg twice per day, orally or IV | 100 mg/dose | Patients with suspected anaplasmosis infection should be treated with doxycycline for 10-14 days to provide appropriate length of therapy for possible incubating co-infection with Lyme disease |
| Children weighing <100 lbs. (45.4 kg) | Doxycycline | 2.2 mg/kg per dose twice per day, orally or IV | 100 mg/dose |
NOTE: Use doxycycline as first-line treatment for suspected anaplasmosis in patients of all ages. The use of doxycycline to treat suspected anaplasmosis in children is recommended by both the CDC and the American Academy of Pediatrics Committee on Infectious Diseases. Use of antibiotics other than doxycycline increases the risk of patient death. At the recommended dose and duration needed to treat anaplasmosis, no evidence has been shown to cause staining of permanent teeth, even when multiple courses are given before the age of eight.
References
Bakken, Johan S., and Dumler JS. Human granulocytic anaplasmosis. Infect Dis Clin North Am 2015:341–355.
Centers for Disease Control and Prevention. Diagnosis and management of tickborne rickettsial diseases: Rocky Mountain spotted fever and other spotted fever group rickettsioses, ehrlichioses, and anaplasmosis—United States: a practical guide for health care and public health professionals. MMWR 2016;65 (No.RR-2).
Engel J, Bradley K, et al. Revision of the national surveillance case definition for ehrlichiosis (ehrlichiosis/anaplasmosis). Council of State and Territorial Epidemiologists, Infectious Diseases Committee, 2007 Position Statement [PDF – 7 pages].
Gelfand JA, Vannier E. Ehrlichia chaffeensis (human monocytotropic ehrlichiosis), Anaplasma phagocytophilum (human granulocytotropic anaplasmosis) and other ehrlichiae. In: Mandell GL, Bennett JE, Dolin R, editors. Mandell, Douglas, and Bennett’s Principles and Practice of Infectious Diseases. 6th ed. Philadelphia, PA: Churchill Livingstone; 2005. p. 2310–2318.
Mowla SJ, Drexler NA, et al. Ehrlichiosis and anaplasmosis among transfusion and transplant recipients in the United States. Emerg Infect Dis. 2021;27(11):2768-2775.
Todd SR, Dahlgren FS, et al. No visible dental staining in children treated with doxycycline for suspected Rocky Mountain spotted fever. J Pediatr 2015;166(5):1246-51.
Wormser GP, Dattwyler RJ, Shapiro ED, et al. The clinical assessment, treatment and prevention of Lyme disease, human granulocytic anaplasmosis, and babesiosis: clinical practice guidelines by the Infectious Diseases Society of America. Clin Infect Dis 2006; 43:1089–1134.